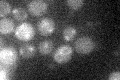
YIL111W

View description
Subunit Vb of cytochrome c oxidase, which is the terminal member of the mitochondrial inner membrane electron transport chain; predominantly expressed during anaerobic growth while its isoform Va (Cox5Ap) is expressed during aerobic growth
Localization:
Intensity:
Fold change:
Significance:
-
C’ GFP library in SD

below threshold12.66 -
N' NOP1pr-GFP in SD

N/A0 -
N' TEF2pr-mCherry in SD

N/A0 -
N' NATIVEpr-GFP in SD

N/A0 -
N' TEF2pr-VC and Cyto-VN in SD

N/A0 -
C’ GFP library in SD+DTT

cytosol15.011.18No -
C’ GFP library in SD+H2O2
cytosol14.131.11No -
C’ GFP library in Starvation Media

cytosol17.141.35No -
C’ GFP library on the background of Pup2-DaMP

below threshold -
C’ GFP library on the background of CCT mutant

below threshold13.11041.03474No
